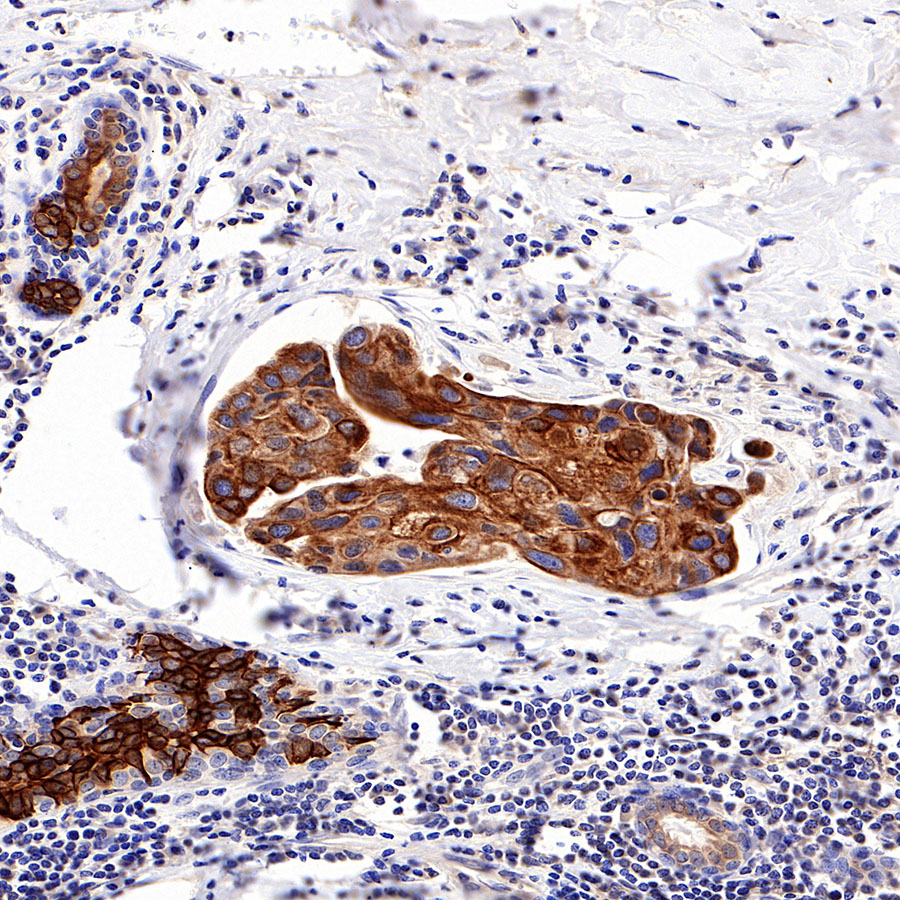

Flow cytometric analysis of 4% PFA fixed 90% methanol permeabilized HeLa (Human cervix adenocarcinoma epithelial cell) cells labelling RRM1 antibody at 1/50 (1 μg) dilution / (red) compared with a Rabbit monoclonal IgG (Black) isotype control and an unlabelled control (cells without incubation with primary antibody and secondary antibody) (Blue). Goat Anti - Rabbit IgG Alexa Fluor® 488 was used as the secondary antibody.
Product Details
Product Details
Product Specification
| Host | Rabbit |
| Antigen | RRM1 |
| Synonyms | Ribonucleoside-diphosphate reductase large subunit, Ribonucleoside-diphosphate reductase subunit M1, Ribonucleotide reductase large subunit |
| Immunogen | N/A |
| Location | Cytoplasm |
| Accession | P23921 |
| Clone Number | SDT-R152 |
| Antibody Type | Recombinant mAb |
| Application | IHC-P, ICC, ICFCM |
| Reactivity | Hu |
| Purification | Protein A |
| Concentration | 0.5 mg/ml |
| Physical Appearance | Liquid |
| Storage Buffer | PBS, 40% Glycerol, 0.05% BSA, 0.03% Proclin 300 |
| Stability & Storage | 12 months from date of receipt / reconstitution, -20 °C as supplied |
Dilution
| application | dilution | species |
| IHC-P | 1:100 | |
| ICC | 1:500 | |
| ICFCM | 1:50 |
Background
The large subunit of human ribonucleotide reductase, RRM1, is involved in the regulation of cell proliferation, cell migration, tumour and metastasis development, and the synthesis of deoxyribonucleotides for DNA synthesis. It is also a cellular target for the chemotherapeutic agent, gemcitabine. RRM1 has been studied in a large number of patients with different types of cancer, such as non-small-cell lung cancer, pancreatic cancer, breast cancer, and biliary tract cancer, to establish its prognostic or predictive value when patients were treated with gemcitabine, and mRNA expression and genetic variants as determined by genotyping have in some cases been associated with clinical outcome of patients with cancer [PMID: 21163702].
Picture
Picture
FC

Immunohistochemistry

Immunocytochemistry

